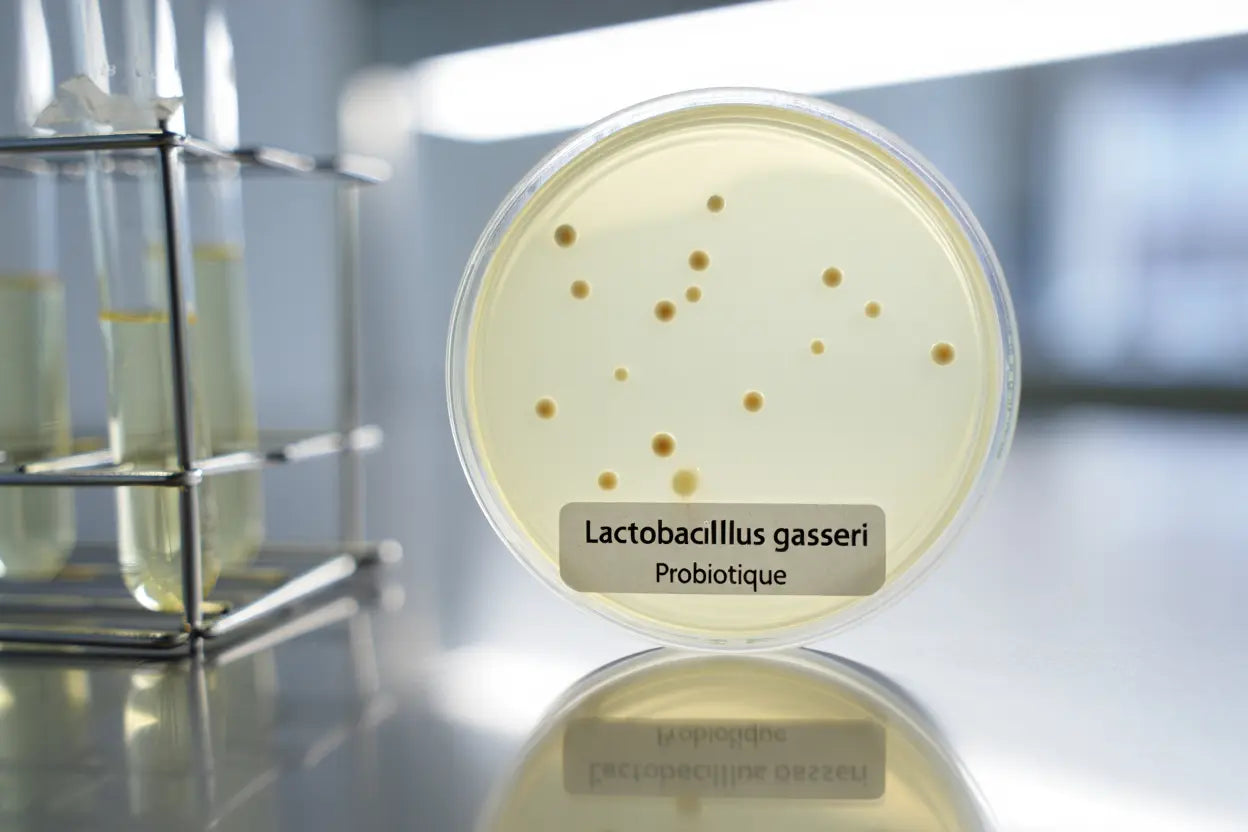
Combien de temps pour voir les effets du lactobacillus gasseri ?

You're probably wondering how long it takes for Lactobacillus gasseri to have an effect on your body. This article explains the realistic timeframes to expect and the key steps to observe the benefits of this probiotic. We help you anticipate the appearance of the first changes and optimize your treatment for lasting results.
First effects of Lactobacillus gasseri: when do they appear?
The first signs of effectiveness of Lactobacillus gasseri generally manifest gradually over the first few weeks. While some people notice slight improvements within 5 to 7 days, others observe clearer changes after about two weeks of regular intake.

Improved digestion from the first week
Lactobacillus gasseri acts quickly on the digestive system, sometimes from the very first days. After about a week, a reduction in bloating and better digestive comfort are often felt, especially if the capsule is taken on an empty stomach.
- Reduction of bloating: The feeling of a swollen stomach gradually subsides during the first week.
- More regular transit: A normalization of intestinal transit can occur between 3 and 5 days for some people.
- Slight initial discomfort: Some gas or gurgling may appear in the first few days, a sign of normal bacterial activity.
- Feeling of lightness: Less digestive fatigue is often perceived after 10 to 14 days.
These rapid improvements are the result of the gradual establishment of good bacteria in the colon. Your digestive comfort improves step by step, which makes daily life much more pleasant.
According to the manufacturer's information, the benefits of Lactobacillus gasseri can manifest from the first few days. However, to obtain lasting results and a significant improvement in the intestinal flora, it is recommended to continue the treatment for several weeks, or even several months. A minimum intake of three months is ideal for anchoring the effects of Lactobacillus gasseri.
To promote rapid action, take your capsule in the morning with cold water, about an hour before breakfast. This morning routine maximizes the survival of bacteria until they reach the intestine.
Intestinal colonization and initial adaptation
The time of action of this probiotic mainly depends on its ability to colonize your intestine. The Lactobacillus gasseri strain begins to establish itself significantly approximately two weeks after the start of the treatment, gradually influencing your intestinal microbiota.
- Gradual establishment: Complete colonization of the colon generally takes between 2 and 4 weeks for optimal action.
- Biofilm formation: A protective barrier naturally develops to strengthen your intestinal flora.
- Microbiota adaptation: Bacterial balance slowly evolves according to your initial state.
- Stabilization of effects: The benefits become more visible and stable after about three weeks of continuous intake.
The use of a gastro-resistant capsule ensures that more than 70% of the colony-forming units arrive alive in your intestine. This accelerates the natural colonization process and allows you to fully enjoy the benefits of Lactobacillus.
Factors influencing the speed of first results
The speed at which effects manifest varies according to your personal and physiological situation. Your age, metabolism, and the initial state of your microbiota explain why some people see results in a week, while others have to wait a little longer.
Recent antibiotic use significantly influences the onset time, as your intestinal flora needs time to rebuild. In this case, a probiotic treatment can extend from 12 to 16 weeks, instead of the usually recommended 8 weeks.
Your lifestyle also affects the time it takes to feel the benefits of Lactobacillus gasseri. A fiber-rich diet and regular physical activity promote colonization, while stress or an unbalanced diet can delay results.
Progressive benefits between 4 and 6 weeks
Between the fourth and sixth week, the intermediate effects of probiotics become more pronounced and measurable. It is often during this period that concrete results are observed, especially if the intake has been regular during this crucial period and the probiotic effect delay is respected.

Appetite control and reduction of cravings
Among these notable effects, a more natural regulation of appetite is observed daily. After about a month of treatment, snacking urges gradually decrease, allowing for better portion management without frustration.
- Increased satiety: The feeling of fullness comes faster and lasts longer after meals.
- Reduction of cravings: Cravings for sugar or fatty snacks become much rarer.
- Increased energy: A natural boost of vitality encourages staying active throughout the day.
- Better digestion: A clear disappearance of post-meal digestive heaviness is noted, simplifying daily life.
This improvement directly results from the positive action of probiotics on the intestinal barrier. By generating specific metabolites, these good bacteria send signals that effectively help modulate the feeling of satiety.
First signs of measurable weight loss
It is common to observe a slight weight loss, generally between 0.5 and 1 kg, during this first month. This result is often due to better elimination of water retention and a significant reduction in bloating.
After this 4 to 6 week period, weight loss tends to stabilize, especially if the diet is balanced. These progressive benefits confirm the deep action on the waistline and the adoption of healthier eating habits.
Optimal results after a 8 to 12 week course
The benefits of Lactobacillus gasseri are fully revealed after a complete course, i.e., between 8 and 12 weeks of daily use. It is during this period that the changes become truly significant and visible. You will notably observe a positive evolution of your waistline and your abdominal fat.

Significant reduction in waist circumference and visceral fat
Research indicates that the effects of this Lactobacillus gasseri strain, particularly the reduction of visceral fat and waist circumference, generally manifest after 8 to 12 weeks of daily intake. Regular consumption, combined with a balanced diet, allows for gradual progress, while immediate results remain unusual.
Clinical studies, particularly those on Lactobacillus gasseri SBT2055, report visible weight loss in visceral fat between the 10th and 12th week. Not only does your figure slim down, but you will also feel more comfortable in your clothes. This reduction specifically targets the fat most harmful to metabolic health.
| Period | Waist circumference reduction | Visceral fat | Overall observation |
| Weeks 1-4 | 0 to 0.5 cm | Slight decrease | Mainly digestive effects |
| Weeks 5-8 | 0.5 to 1.5 cm | Moderate reduction | First visible weight results |
| Weeks 9-12 | 2 to 4 cm | Significant reduction | Stable and measurable results |
Recommended duration for lasting effects
For effective weight loss and a deep restructuring of your microbiota, it is essential to maintain this effort over the long term. A 3-month course, or about 90 days, allows you to rebalance your intestinal flora and strengthen the intestinal barrier. This consistency is key to fully enjoying the benefits over time.
After about 10 weeks, most users observe a stabilization of their weight as well as a noticeable decrease in fat mass. These results are part of a progressive and lasting improvement, rather than sudden variations. This approach guarantees a better consolidation of the achievements obtained thanks to this probiotic.
- Recommended standard course: Follow a course of 8 to 12 consecutive weeks for measurable and lasting results.
- Stabilization after 12 weeks: Effects generally consolidate at this stage.
- Lifestyle maintenance: Combine a fiber-rich diet and regular physical activity daily.
- Possibility of prolongation: Some severe imbalances may require a course of up to 24 weeks for full recovery.
If good eating habits are not maintained after the course, a gradual weight regain may occur. It is therefore crucial to adopt a lasting change in your routine, in parallel with taking Lactobacillus gasseri. Regularity, week after week, remains your best ally.
Clinical evidence and measurable results
Clinical studies confirm the benefits of Lactobacillus gasseri, particularly those associated with the Lactobacillus gasseri SBT2055 strain. The data collected show a real, though modest, reduction in abdominal fat in participants. These observations also include a measurable decrease in waist circumference.
This research demonstrates that this probiotic is an effective support, but it is not a miracle solution in isolation. Effects vary from individual to individual, depending on the formulations and adherence to protocols. Each organism reacts differently to supplementation with Lactobacillus gasseri.
Probiotic intake and maintenance protocol
To maximize the benefits of your supplement and ensure the expected results, it is essential to master the probiotic protocol. Here we detail the ideal dosage and the strategies to adopt to ensure optimal effectiveness of your treatment over time.
Optimal dosage and daily intake methods
It is generally recommended to take one capsule per day, providing between 10 and 15 billion CFUs. This precise dose, especially if the capsule is gastro-resistant, allows the good bacteria to arrive alive in your colon to deploy all their beneficial effects.
Maintenance schedule after the initial course
After completing your initial 8 to 12-week course, the maintenance phase is crucial to preserve the effects. We advise you to adopt a lighter rhythm, such as taking a capsule every other day instead of daily.
- Initial course: Take one capsule daily for 8 to 12 weeks to initiate the active phase.
- Maintenance phase: Continue with one capsule every other day for 3 to 6 months to consolidate the results.
- Repeated cycles: After a one-month break, resume daily dosing for one month if necessary.
- Optimal storage: Store the product away from heat and humidity to preserve the quality of the probiotic strains.
If you do not follow this maintenance schedule or abandon a fiber-rich diet, the benefits will gradually fade within 4 to 6 weeks. A complete cessation coupled with poor eating habits could bring you back to square one in the same amount of time.
Key factors for maximizing lasting results
The success of your protocol depends on several elements: your diligence, your diet, your level of physical activity, and your lifestyle. To fully feel the effects of the probiotic, it is essential to take your dose every day without interruption during the first 12 weeks.
Try to add 10 to 20 grams of soluble fiber or prebiotics, such as inulin, to your meals daily. These nutrients serve as food for your probiotics, facilitate their implantation, and help you enjoy the benefits of lactobacillus one to two weeks earlier. In parallel, engage in at least 150 minutes of physical activity per week and ensure the quality of your sleep to enhance the overall effectiveness of your treatment.
Frequently Asked Questions
How long exactly does it take to observe the first effects of a Lactobacillus gasseri probiotic?
The first signs on digestion, such as a reduction in bloating, can be felt as early as 5 to 7 days. For more pronounced effects on weight management, it is generally necessary to wait between 2 and 4 weeks. This time corresponds to the period required for the probiotic strain to fully colonize your intestinal microbiota.
This delay varies depending on the initial state of your microbiota and your metabolism. Strict adherence to the daily dosage also greatly influences the speed of appearance of results. Each person reacts differently to the Lactobacillus gasseri probiotic.
Can weight loss results with Lactobacillus gasseri BNR17 be seen before 8 weeks?
Yes, slight weight loss (generally 0.5 to 1 kg) can be observed between 4 and 6 weeks. This change is often accompanied by a better feeling of satiety and a visible reduction in bloating. However, significant results on waist circumference often require a little more time.
The full effectiveness of Lactobacillus gasseri BNR17 is generally observed after 8 to 12 weeks of continuous treatment. This duration is crucial to allow for a deep rebalancing of your microbiota. It is necessary to give the dosage time to act sustainably.
What happens if I stop my probiotic treatment before 8 weeks?
Interrupting your treatment too early risks reducing the benefits to simple temporary digestive improvements. Without follow-up, your microbiota tends to return to its initial state within 3 to 4 weeks. A minimum duration of 8 to 12 weeks is therefore essential to durably restructure your intestinal flora.
After this phase, a maintenance strategy (such as one capsule every other day) can be adopted. Combined with an adapted diet, it allows you to preserve the long-term results without having to restart an intensive treatment. This is the key to maintaining the benefits day after day.

Leave a comment
This site is protected by hCaptcha and the hCaptcha Privacy Policy and Terms of Service apply.